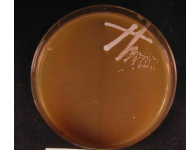
�C���[�W01

分子レベルで,生命機能を解析し,新しい細胞機能を作る。
酵母や微生物,ヒト培養細胞を対象に、「遺伝子」「タンパク質」を操作して生命を化学的な視点で理解し、それらを人々や地球のために遺伝子工学的手法を用いて利用することを目指しています。
ギャラリー
informationお知らせ
- 2026年3月20日
- 赤田先生の退職に合わせて祝賀会と同窓会を開催しました。
- 2025年12月15日
- 耐熱性酵母の糖アルコール輸送体と代謝酵素の論文が受理されました。マンニトール代謝の酵素の同定は難しかった。
- 2025年8月28日
- 耐熱性酵母のセロビオース輸送体の論文が受理されました。C末端を削るとよりアクティブに。
- 2025年6月12日
- 企業と進めていた共同研究成果の論文が受理されました。発酵にはアスパラギン酸とpHが大事。
- 2025年4月7日
- イントロンによる発現増強に関与する遺伝子をゲノムワイドに探索した論文が受理されました。
- 2024年8月20日
- タイの大学で学生向けのワークショップを開催しました。
- 2023年8月25日
- TCTTによる発現抑制とイントロンによるその解除の論文が受理されました。
- 2021年12月16日
- 発現増強に必要なイントロン配列を解析した論文が受理されました。
- 2021年8月10日
- Kluyveromyces marxianus 自律複製配列の論文が公開されました。
- 2020年11月28,29日
- The17th Young Scientist Seminarをオンラインで開催しました。
- 2020年11月18日
- Candida菌の菌糸形成阻害の論文が公開されました。
- 2020年10月16日
- Kluyveromyces marxianus のマイトファジーの論文が受理されました。
- 2020年7月20日
- コロナウイルス感染防止シールド作製中。
- 2020年4月16日
- 研究室カルタヘナ講習会をオンラインで実施。
- 2020年4月1日
- 新年度がスタート。新しい4年生を研究室に迎えました。
- 2020年3月24日
- 卒業式の予定だった日。
- 2020年2月20日
- 修士論文発表会と卒業記念パーティー。
- 2020年2月4日
- 今年度は4年生が先に卒業論文発表。
profile
山口大学
工学部 応用化学科
大学院 創成科学研究科
分子生命機能工学研究室
〒755-8611
山口県宇部市常盤台2-16-1